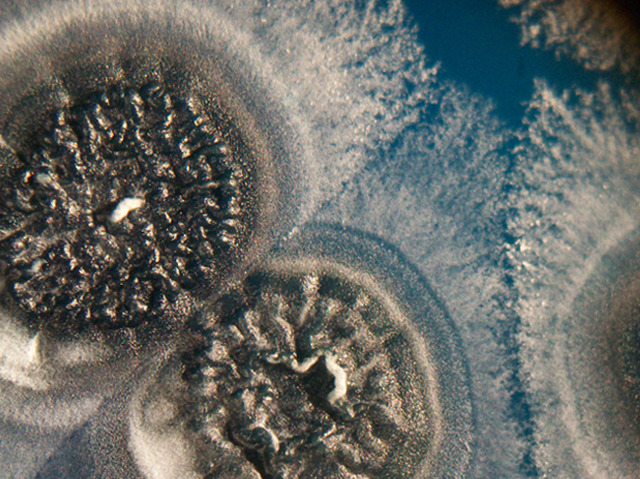

25 November 2013
Precious Secretions
Actinobacteria, such as Streptomyces, are a treasure trove for scientists as they naturally produce a host of medicinal compounds, including antibiotics, antifungals and anticancer agents. Normally found in soil, researchers have discovered that Streptomyces can be forced to secrete new and different substances, simply by changing their surroundings. For example, growing Streptomyces coelicolor in a salty environment subjects the bacteria to osmotic stress, producing a brilliant blue antibiotic that dramatically alters the appearance of the culture (pictured). Recently biologists have found that growing Streptomyces coelicolor alongside other bacteria can stimulate the production of numerous compounds that are not found when the bacterium is grown alone. Researchers hope that such techniques can be used to mine the bacteria for new treasures in the form of novel therapeutic compounds.
Written by
Search The Archive
Submit An Image
Like us on Facebook
Follow on Twitter
Follow on Tumblr
Follow on Instagram
What is BPoD?
BPoD stands for Biomedical Picture of the Day. Managed by the MRC Laboratory of Medical Sciences until Jul 2023, it is now run independently by a dedicated team of scientists and writers. The website aims to engage everyone, young and old, in the wonders of biology, and its influence on medicine. The ever-growing archive of more than 4000 research images documents over a decade of progress. Explore the collection and see what you discover. Images are kindly provided for inclusion on this website through the generosity of scientists across the globe.
BPoD is also available in Catalan at www.bpod.cat with translations by the University of Valencia.








